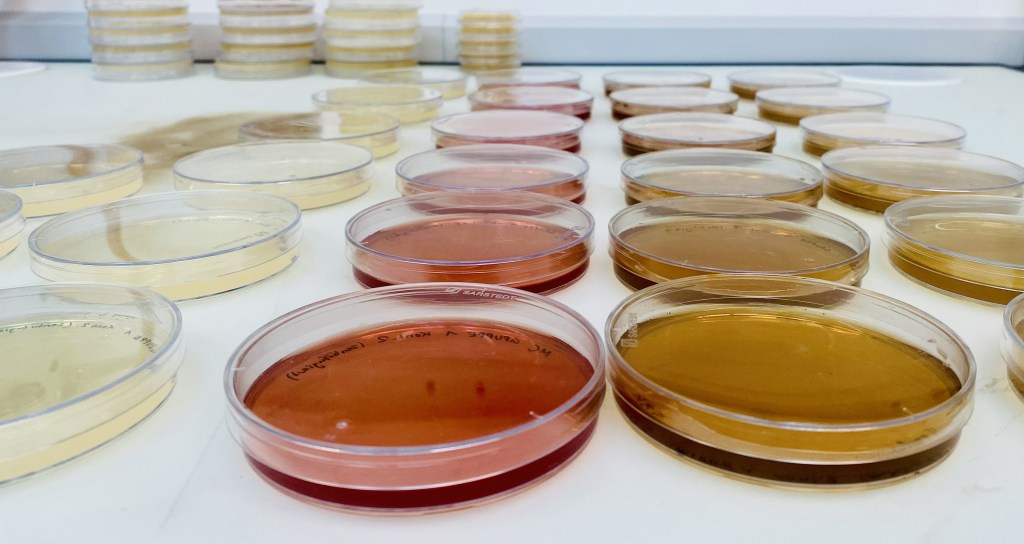

Quantitative host-microbiota physiology
Welcome to the pages of Markus Arnoldini’s lab at ETH Zürich! We use a combination of experiments and mathematical modeling to understand how the microbes living in and on the human body influence our health, and how our bodies’ functions influence them.